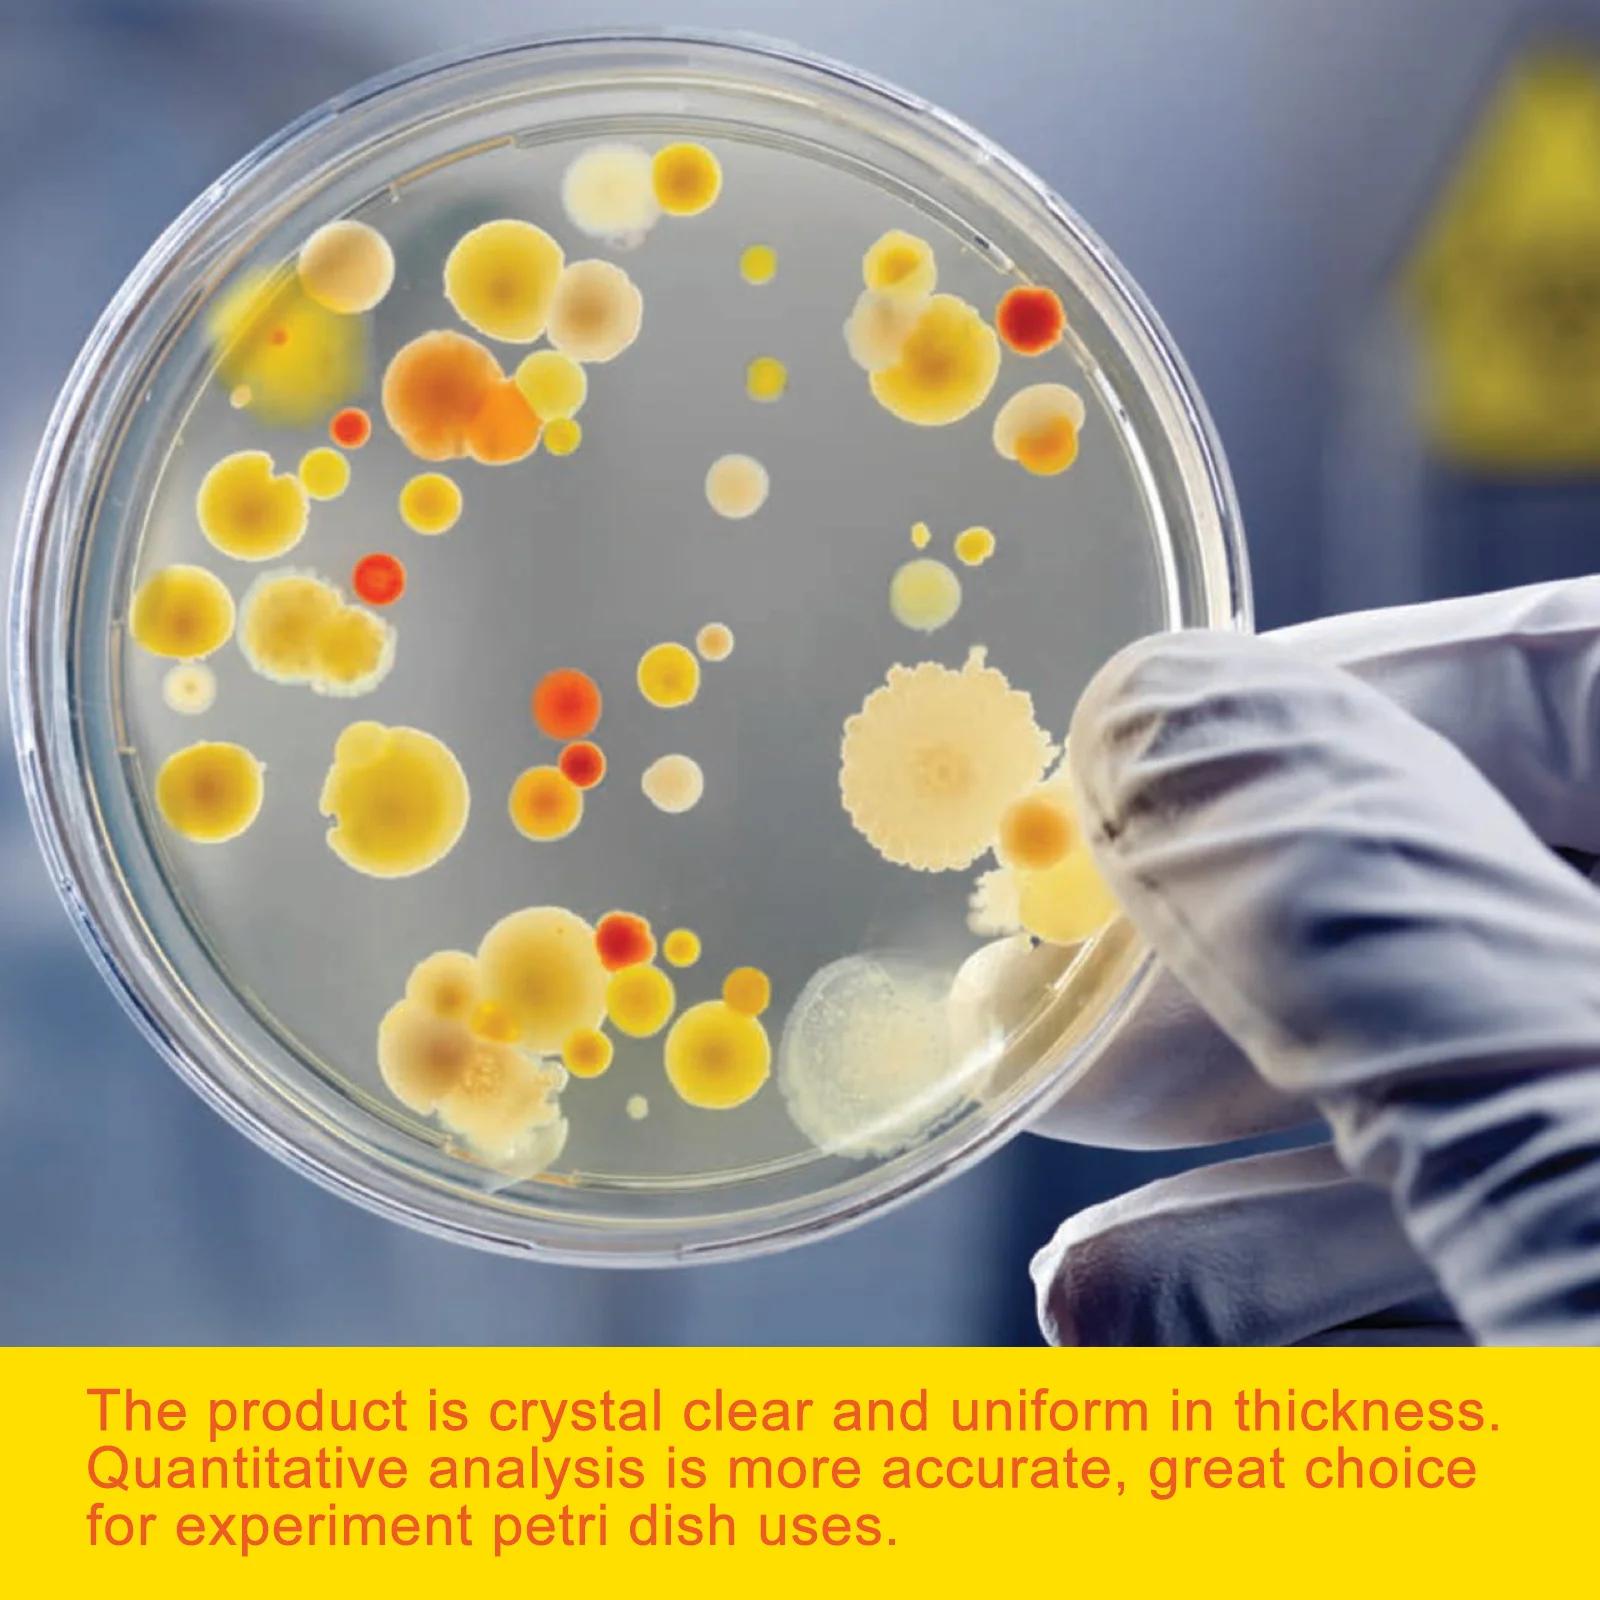
30Pcs Sterile Plastic Petri Dishes Clear Uniform Thickness for Accurate Quantitative Analysis Petri Dishes Culture Dish 
30Pcs Sterile Plastic Petri Dishes Clear Uniform Thickness for Accurate Quantitative Analysis Petri Dishes Culture Dish

Портативна коробка для зберігання їжі Прозора коробка для упаковки м’яса Кухонне приладдя 370ml
График изменения цены & курс обмена валют
Пользователи также просматривали

340.66 грн.
My Hero Academia Dabi Tapestry Room Decor Wall Cloth Party Hanging Background Room Decor Baby Room
aliexpress.com
746.60 грн.
Car Glow Plug Bridge Wiring Harness for - Transporter 2.5 TDI 2003-2010 070971277B
aliexpress.com
6,032.09 грн.
Зеркало с гравировкой в раме 59x77см Evoform BY 4032 травленая бронза, Коричневый, BY 4032
goods.ru
1,589.88 грн.
Цветочный ковер в стиле ретро для гостиной, марокканский ковер для спальни, кофейного столика, коврик для кабинета, напольный коврик для ресторана, скандинавский ковер
aliexpress.ru
376.23 грн.
IKKI "3300mAh" External Battery Power Charger for Samsung S3 Mini i8190 / Xcover 2 - Golden
dx.com
4,072.01 грн.
Часы Sea knight Sharkey Monster Automatch NH36A Sapphire Glass C3, светящиеся Мужские механические часы для дайвинга 200 м
aliexpress.ru
808.12 грн.
Женская футболка для йоги CAEEMHEE, спортивный топ с коротким рукавом, свободный Быстросохнущий кроп-топ для бега, фитнеса, тренажерного зала, б...
aliexpress.ru
1,567.28 грн.
5X FT08 RC 150A High Precision Watt Meter And Power Analyzer With Backlight LCD
aliexpress.com
1,018.21 грн.
Оконная кормушка для птиц уличная кормушка для птиц, для диких птиц, для голубых птиц, другая акриловая кормушка для домашних животных
aliexpress.ru
180.37 грн.
Art Wall Sticker Lashes Salon Eyelashes Decor Vinyl Removeable Beauty Salon Decoration Make up Extensions Eyebrows Decal LY265
aliexpress.ru
1,043.32 грн.
100% New Original 36v 12.8Ah lithium battery 10s2p 36v battery 12800mAh lithium ion pack 42V 12800mah scooter twist car battery
aliexpress.com
10,050.00 грн.
Двужильный нагревательный мат Nexans Millimat/150 1050 Вт 7 м2. Комплект с терморегулятором
rozetka.com.ua
603.90 грн.
New Generation Black Single Ear Headset Microphone 3.5mm Jack External Lock For Wireless System PC Omnidirectional Mic
aliexpress.ru
319.32 грн.
30Pcs Sterile Plastic Petri Dishes Clear Uniform Thickness for Accurate Quantitative Analysis Petri Dishes Culture Dish
aliexpress.ru
349.03 грн.
1 set 1 Set Silicone Oven Mitts Pot Holder Heat Resistant For Cooking Baking Microwave Use Kitchen Accessories Oven Mitts Set
aliexpress.ru














